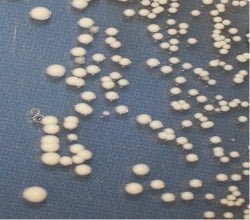

Noruega.- La micobacteriosis en peces es una enfermedad que es difícil de detectar y frecuentemente es subdiagnosticada. Por la misma razón, la información sobre los efectos de esta enfermedad en la piscicultura es limitada.
El desarrollo de dos pruebas de diagnostico ha conducido a descubrir una micobacteria que causa enfermedades en el bacalao y salmón, y nunca ha sido detectado antes en Noruega.
Los informes enviados a las autoridades de la micobacterioris (tuberculosis) en peces han sido esporádicos y sólo provienen de los peces de acuario o peces silvestres. Esto probablemente se debe a un subdiagnóstico.
La investigación doctoral de Adam Zerihun permitió el desarrollo de dos métodos de diagnóstico basados en PCR de tiempo real e inmunohistoquímica, respectivamente. Las pruebas son extremadamente sensibles y han sido fundamentales en la detección de una micobacteria que nunca se ha encontrado antes en Noruega. Las bacteria fue hallada tanto en el salmón de cultivo y en la lota, y la infección experimental mostró que el bacalao del Atlántico fue muy susceptible a las bacteria y se enfermaron. La bacteria aislada se identificó como Mycobacterium salmoniphilum.
En el bacalao y lota infectados con M. salmoniphilum, Zerihun descubrió serios nódulos graves, mientras que en el salmón del Atlántico infectado sólo pequeños o ningún cambio fueron hallados. La formación de nódulos en bacalao mostraron varias fase de desarrollo. La identificación y caracterización de estos diferentes estados son importantes para la evaluación del desarrollo de la enfermedad y con la finalidad de estimar el tiempo de infección. El estudio de Zerihun indica que la ocurrencia de la enfermedad en el salmón del Atlántico de cultivo y el bacalao es más extendida de los que se pensaba, con respecto al rango de huéspedes y las variaciones climáticas.
Debido a que la formación de nódulos no es un síntoma típico del salmón infectado con M. salmoniphilum, es altamente probable que en muchos casos de tuberculosis en el salmón queden sin descubrir. Los peces que pierden peso sin ninguna enfermedad aparente o causa específica se clasifica en acuicultura como “pez perdido”. Una infección por micobacterias puede estar al acecho detrás de varios síntomas diferentes, donde la pérdida de peso es una de las características.
Por esta razón, muchos salmones infectados con tuberculosis puede ser una de las razones no detectadas para las pérdidas en la industria. El estrés que se incrementa cuando muchos peces se mantienen juntos debilita su sistema inmune y permite a las micobacterias reproducirse en muchos individuos. Estos factores son conocidos por promover la ocurrencia de la micobacteriosis.
Mulualem Adam Zerihun defendió su investigación doctoral en 11 de enero de 2013 en la Norwegian School of Veterinary Science con la tesis titulada: “Mycobacteriosis in marine and freshwater fishes: characterization of the disease and identification of the infectious agents”.
Contacto:
Mulualem Adam Zerihun
Tel.: + 47 67 53 92 95
Tel. work: + 47 23 21 64 40
Mobile: + 47 415 09 453
Email: adam.zerihun@vetinst.no
Editor de la revista digital AquaHoy. Biólogo Acuicultor titulado por la Universidad Nacional del Santa (UNS) y Máster en Gestión de la Ciencia y la Innovación por la Universidad Politécnica de Valencia, con diplomados en Innovación Empresarial y Gestión de la Innovación. Posee amplia experiencia en el sector acuícola y pesquero, habiendo liderado la Unidad de Innovación en Pesca del Programa Nacional de Innovación en Pesca y Acuicultura (PNIPA). Ha sido consultor senior en vigilancia tecnológica, formulador y asesor de proyectos de innovación, y docente en la UNS. Es miembro del Colegio de Biólogos del Perú y ha sido reconocido por la World Aquaculture Society (WAS) en 2016 por su aporte a la acuicultura.
Mantente siempre informado
Únete a nuestras comunidades para recibir al instante las noticias, informes y análisis más importantes del sector acuícola.




